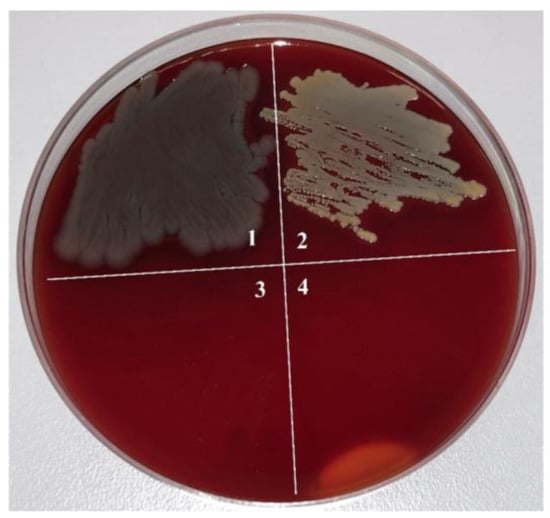

Abstract
In this work, approaches to the formation of multifunctional film heterostructures based on noble metals for the modification of the surface of implant materials (titanium alloy TiAl6V4 and carbon-fiber-reinforced polyetheretherketone CFR-PEEK) are developed. Such heterostructures consist of continuous layers of platinum (Pt) or iridium (Ir) and antibacterial components on their surface, namely silver (nanoparticles or discontinuous films) and gold (nanoparticles). Chemical or physical gas-phase deposition methods were used for their preparation. The influence of the concentration and form of the antibacterial component on the antibacterial activity and in vivo biocompatibility of the film structures was evaluated for the first time. Differences in the dynamics of silver dissolution depending on Ag concentration in the sample and the type of bottom surface (the noble metal layer = Ir, Pt or TiAl6V4) surfaces allowed us to better understand the nature of the antibacterial action against Staphylococcus aureus and Pseudomonas aeruginosa (S. aureus and P. aeruginosa) of Ag/M heterostructures. From in vivo histological studies using rats, the best biocompatibility was shown by the Ag/M heterostructure with a prolonged release of the low fraction of antibacterial component (Ag).
1. Introduction
Current trends in the development of implantation are associated with the creation of new biosystems capable of performing several functions, including stimulation of tissue regeneration and prevention of adverse reactions and inflammatory infections [1,2]. In orthopedic, reconstructive and oncological medicine, titanium and its alloys are traditionally used as materials for implants, but the possibilities of active use of low-toxic polymers reinforced with carbon fiber, viz. carbon-fiber-reinforced polyetheretherketone (CFR-PEEK), are also being considered [3,4]. However, when developing biomaterials, the problem of peri-implantation inflammation associated with the formation of bacterial biofilms on the implant surface and, as a consequence, the development of infections is particularly acute [1]. Infections can lead to serious complications, including surgical revision and prolonged antibacterial therapy. In this regard, one of the solutions to the problem of increasing the effectiveness of permanent implants is the functionalization of the surface of the biomaterial with film heterostructures that can not only improve their biointegrating properties, but also provide a prolonged antibacterial effect [5]. Examples of such heterostructures are nanomaterials based on films or nanoparticles of noble metals and nanoparticles of Ag or Au [6,7,8,9].
According to the published data [7,10], the anti-bacterial properties of silver-based materials are largely related to the process of release of silver ions, the control of which is important for determining a safe dose for humans [11].
Uncontrolled release of silver is associated with the following factors: the size and shape of Ag structures and particles, their stability, crystallinity and reactivity which can have an adverse effect on the body. Köller et al. [12,13] showed that the use of noble metals, especially Ir, as an anode pair to Ag, accelerates the release of silver ions and fully inhibits the growth of S. aureus colonies. The influence of Ag particle sizes, their concentration, dispersion and distribution on the processes of silver ion release is still a subject of discussion [10,14,15].
The factors affecting the antibacterial activity of AuNPs have not been practically studied. The literature mainly presents the results of the antibacterial activity of solutions with gold nanoparticles [16]. In particular, small AuNPs (<10 nm) cause an approximately three-fold increase in intracellular production of reactive oxygen species (ROS) compared to the control group [17]. This is due to their high reactivity, which leads to the oxidative dissolution of metallic gold with the release of Au ions biologically active media [18]. On the contrary, the bulk gold (Au) is known to be chemically inactive and does not dissolve in the biologically active media [19]. Summing up the reports [16,17,18,20], it can be expected that the antibacterial activity of heterostructures with gold particles will be dependent on AuNPs size.
In this work, a series of Ag/M and Au/M (M = Ir, Pt) film heterostructures were obtained by the methods of physical and chemical vapor deposition (PVD and MOCVD, respectively) on the Ti-alloy and CFR-PEEK surfaces. For the Ag/M and Au/M series, the effect of Ag and Au particle sizes, their surface concentration, type of heterostructure and implant material on their antibacterial activity and in vivo biocompatibility were studied.
2. Materials and Methods
2.1. Materials
The following volatile metal complexes were used as precursors for MOCVD processes: Ir(cod)(acac), Ir(CO)2(acac), Pt(acac)2, (CH3)3Pt(acac)Py, [Ag(cod)(hfac)]2 (cod = cyclooctadiene-1,5; acac = acetylacetonato-ion, hfac = hexafluoroacetylacetonato-ion).
Precursors used for MOCVD of Ir and Pt films, namely Ir(cod)(acac), Ir(CO)2(acac), Pt(acac)2, (CH3)3Pt(acac)Py (cod = 1,5-cycloocadiene, Py = pyridine), were synthesized using standard methods described in our previous works [21,22]. For MOCVD of AgNPs, [Ag(cod)(hfac)]2 was synthesized by the reaction of an aqueous solution containing 0.402 g (2.4 mmol) of AgNO3 (99.9%, JSC LenReactiv, St. Petersburg, Russia, CAS 7761-88-8) and 0.29 mL (2.4 mmol) cod (99%, Dalchem, CAS 111-78-4) with an aqueous solution of 0.544 g (2.4 mmol) of Na(hfac) (97%, Sigma Aldrich, CAS 22466-49-5). The Pt and Ir precursors were purified by zone sublimation (10−2 Torr, 80–160 °C). The product was purified by recrystallization from CH2Cl2 (−30 °C); the yield was 74%. All compounds were characterized by elemental analysis (CARLO-ERBA-11008 analyzer, Euro EA3000 analyzer (Eurovector, Pavia PV, Italy), Cary-60 spectrophotometer (Agilent, Santa Clara, CA, USA) [23]) and melting point (m.p., Kofler table) (Table 1). For PVD of AgNPs and AuNPs, the metallic Ag (>99.9%) granules and Au (>99.9%) powder provided by NAZ (Novosibirsk Refinery) Ltd., Novosibirsk, Russia were used.

Table 1.
Characterization of Pt, Ir and Ag precursors.
Commercially available medical implant materials were used as substrates:
- Medical Ti-alloy (further on referred to as “Ti”): Ti6Al4V, discs with a diameter of 10 mm, thickness of 2 mm or plates 5 × 10 mm2, Baoji Chenyuan Metal Materials Co., Ltd., Baoji, China;
- Carbon-fiber-reinforced polyetheretherketone (further on referred to as “CFR-PEEK”): carbon fiber content 30%, discs with a diameter of 30 mm, thickness of 2 mm produced by Jiangsu Junhua High Performance Specialty Engineering Plastics (Peek) Products Co., Ltd., Changzhou, China.
2.2. Implant Surfaces Functionalization
Ir and Pt films were deposited on medical implant materials according to the MOCVD deposition procedures developed in our previous works [21,22] using a hand-made vertical reactor with cold walls equipped with an Xe lamp (vacuum ultraviolet, VUV, λ = 113 nm) (CHROMDET Analytical Instrument Ltd, Moscow, Russia) at reduced pressure (2 Torr). Before the deposition process, the CFR-PEEK discs were heated in the MOCVD reactor at 280 °C for 30 min under VUV radiation. The deposition conditions are summarized below:
- Ir/Ti carrier samples (Ir film on Ti disc): Ir(cod)(acac) precursor (load 60 mg), deposition temperature (Td.) = 310 °C, evaporator temperature (Tevap.) = 110 °C, flow rates of both carrier gas (v(Ar)) and reactant gas (v(O2)) = 2 L/h, deposition time = 2 h;
- Ir/CFR-PEEK carrier samples (Ir film on CFR-PEEK disc): Ir(CO)2(acac) precursor (load 80 mg), Td. = 320 °C, Tevap. = 83 °C, v(Ar) = v(O2) = 2 L/h, deposition time = 4 h;
- Pt/Ti carrier samples (Pt film on Ti disc): Pt(acac)2 precursor (load 55 mg), Td. = 310 °C, Tevap. = 150 °C, v(Ar) = 2 L/h, v(O2) = 1 L/h, deposition time = 2 h;
- Pt/CFR-PEEK carrier samples (Pt film on CFR-PEEK disc): (CH3)3Pt(acac)Py precursor (load 100 mg), Td. = 320 °C, Tevap. = 105 °C, (Ar) = 2 L/h, v(O2) = 1 L/h, deposition time = 4 h.
Ag and Au nanoparticles were deposited on Ti, CFR-PEEK and Ir-, with Pt-coated Ti and CFR-PEEK substrates by MOCVD and PVD (Table 2).

Table 2.
Deposition conditions of AgNPs and AuNPs and the sample designations.
Within the PVD method, the surface concentration of Ag or Au in the series of heterostructures was varied by changing only the mass of the loaded metal (Table 1, column 3). The samples deposited at the smallest Ag or Au loads were designated as “s-ones”, while their analogues obtained at the highest Ag or Au loads were designated as “b-ones” (Table 2, column 7).
2.3. Methods
The characterization of samples (Table 2) was performed using a set of standard methods, including the following:
- XRD = X-ray diffraction (a Shimadzu XRD-7000 diffractometer, Shimadzu, Kyoto, Japan, CuKα radiation (2θ = 10–65°)). XRD patterns were indexed according to the RDF-2 database (ICDD, Newtown Square, USA) (version 2022);
- SEM = Scanning Electron Microscopy (JEOL-ISM 6700 F microscope, Tokyo, Japan and HITACHI UHR FE-SEM SU8200, Hitachi, Ltd., Hitachi, Japan). SEM images of the samples (Tiff files) were imported into the program image analysis software (ImageJ) National Institutes of Health, 9000 Rockville Pike, Bethesda, Rockville, MA, USA (version 2.0.0). During image processing, data on scale were entered and the particle size distribution in the samples were determined using plugins proposed in [25];
- XPS = X-Ray photoelectron spectroscopy (PHOIBOS-150 analyzer (SPECS, Berlin, Germany) with 1D-DLD detector, FOCUS-500 monochromator (SPECS, Berlin, Germany), Al Kα radiation, hv = 1486.71 eV, 14 kV, 200 W). The binding energy scale (Eb) was calibrated using the valence band spectra (0.0 eV). The spectra were processed in the CASA program (Casa Software Ltd., Devon, UK) (version 2.3.24) using the Lorentzian Asymmetric Lineshape with Tail Damping. The background was taken into account using the Shirley method.
2.4. Determination of Ag and Au Content and Dynamic of Ag Ions Release
The determination of Ag and Au content and dynamics of Ag ions release was performed using ICP-AES inductively coupled plasma atomic emission spectroscopy (iCAP 6500, Thermo Fisher Scientific, Waltham, MA, USA). Ag samples were dissolved in concentrated nitric acid, while Au samples were dissolved in a mixture of concentrated hydrochloric and nitric acids (3:1). The resulting solutions containing Ag or Au ions were injected into the plasma through a SeaSpray-type nebulizer. The registration was performed under the following conditions: Ar flow rate—12 L/min, secondary—0.5 L/min, registration time—5 s and power supplied to ICP inductor—1150 W.
Standard solutions of gold (standard solution of gold MSDS, 170216, Merck, Rahway, NJ, USA), silver (standard solution of silver, MSDS, 119797, Merck, Rahway, NJ, USA), plastic tubes of 15 and 50 mL and automatic pipettes of variable volume (1.00–5.00 mL, 100–1000 mL, 10–100 mL) were used for sample preparation. The most intense analytical lines (without spectral interference) were used for interpretation: 208.209, 242.795, 267.595 nm for Au and 328.068, 338.289 nm for Ag.
The dynamic of Ag ions release was studied for s-Ag/Ti, s-Ag/Ir/Ti, s-Ag/Pt/Ti and b-Ag/Ir/Ti samples (Table 2). In each case, a series of identical samples were prepared on Ti plates and loaded into separate containers. A total of 5 mL of phosphate-buffered solution (0.01M PBS, pH = 6.8) was added to each container; then, the containers were sealed and stored for 2, 4, 8, 12, 24, 36 and 48 h. The spectrum of the sample was recorded at each time point.
2.5. Biological Studies
2.5.1. Antibacterial Activity of Samples
To study the antibacterial activity of samples (Table 2), the pure S. aureus and P. aeruginosa cultures were used. The standard solutions containing 2 × 106 CFU/mL each were prepared in RPMI-1640 medium (Thermo Fisher Scientific, Waltham, MA, USA) with the addition of 0.3 g/L L-glutamine and 2 g/L sodium bicarbonate (Thermo Fisher Scientific, Waltham, MA, USA), and samples were placed in wells of a 6-well plate. The bacterial suspension (50 μL) was applied as a drop to each test sample and incubated in a humid thermostat at 37 °C. The next day, a drop of bacterial suspension from the sample was transferred to a Petri dish with appropriate culture medium and cultured further for 24 or 48 h to evaluate bacterial growth. Bacterial colonies were stained with Hoechst 33,342 fluorescent dye (Thermo Fisher Scientific, Waltham, MA, USA) and counted using an Axioskop 40FL microscope (Carl Zeiss, Jena, Germany). Measurements in each experimental group were performed in three repetitions.
Data on antibacterial activity of samples were expressed as means ± standard deviation (SD). The statistical analysis and significance were evaluated using a one-way analysis of variance (ANOVA) followed by a post hoc Tukey test. All analyses were performed using a Statistica 13 software (TIBCO Software, Palo Alto, CA, USA) (version 13.0). Differences between the control and treated samples were considered significant at p < 0.05.
2.5.2. Investigation of Local Inflammatory Reactions
The Local Ethics Committee of the «E. Meshalkin National Medical Research Center» of the Ministry of Health of the Russian Federation approved all in vivo biocompatibility and histological studies. All parts of the protocol were implemented according to the recommendations on the proper use and care of laboratory animals (European Communities Council Directive 86/609/CEE and the principles of the Declaration of Helsinki). Fifteen pairs of prepared specimens were implanted subcutaneously in Wistar rats (male, weight 100–120 g) obtained from the laboratory animal facility of the Institute of Cytology and Genetics Siberian Branch of Russian Academy of Sciences (Novosibirsk, Russia). The animals were housed in the vivarium of «E. Meshalkin National medical research center» of the Ministry of Health of the Russian Federation with free access to water and commercial laboratory chow. A 12 h light regime and cleaning according to regulatory requirements were maintained. Animals were acclimatized for 7 days prior to the start of the experiment and were examined daily.
Samples without heterostructure coatings were used as controls. Sham operations were not provided.
To study the local inflammatory reactions, CFR-PEEK discs with heterostructures and a bare disk were implanted into laboratory animals (rats) according to the conventional methods under anesthesia in the operating room in compliance with the rules of asepsis and antiseptics. A combination of atropine and zoletil-100 (30 mg/kg Zoletil-100, Virbac, Carros, France) natrimuscularly was used for anesthesia. The dosage in each case was chosen based on the weight of the animal. The depth of anesthesia and its course were controlled by the reaction of pupils to light, while the heart rate and respiratory rate were monitored. At the surgical stage of anesthesia, when a sanitary shaving of the wool in the area of the back was performed (a field about 5 × 9 cm), the animal was fixed on the operating table in the “abdomen” position. The surgical field was treated with an antiseptic solution, and lateral to the spine a longitudinal skin incision up to 10 mm long was made. Through the incision with a blunt using surgical scissors, a pocket was formed in the subcutaneous tissue where the test specimen was placed. The skin incision was sutured with an absorbable surgical thread and treated with an antiseptic solution. The animals were moved into cages for further observation.
2.5.3. Histological Studies
The samples implanted into the rats (see details in Section 2.5.2) together with the surrounding tissues were removed after 1 and 3 months for histological studies. Six-micrometer sections of formalin-fixed paraffin specimens were prepared using an HM340 microtome (Microm, Walldorf, Germany) and stained with hematoxylin–eosin. An Axioskop 40FL microscope (Carl Zeiss, Oberkochen, Germany) equipped with the AxioVision version 4.7 software (Carl Zeiss, Oberkochen, Germany) was used for the morphological studies. The following system (scale of 0–3 points) was used to estimate the morphohistological changes during histological experiments:
- Packing density: The minimum value is 0 (the arrangement of fibers at a distance of the width of one standard collagen fiber, cells presented only by fibroblast row with density as in a healthy loose connective tissue).
- Microvessels: The minimum value is 0 (the low number of microvessels corresponds to lose connective tissue in the subcutaneous layer).
- Macrophages: The minimum value is 0 (the low number of macrophages which normally circulate in the bloodstream, but their concentration in the tissue increases in the presence of attractant (stimulus)).
- Lymphocytes: The minimum value is 0 (the low number of lymphocytes which normally circulate in the blood and/or lymphatic stream, while their concentration significantly increases in the tissue only in the case of the appearance of the attractant with a long enough presence in the tissue).
- Foreign body cells (FBCs): The minimum value is 0 (the FBCs are normally absent, the forming CITs the body are trying to isolate the given object from the tissues).
- Mast cells (tissue basophils): The minimum value is 0 (the low number of tissue basophils which are present in the tissues; the number may increase in the presence of irritants and take part in the development of allergic and anaphylactic reactions).
3. Results
3.1. Characterization of Ir and Pt Coatings Modified with Au Nanoparticles (AuNPs)
To study the effect of the size and concentration of AuNPs on the antibacterial activity of film heterostructures, two series of samples on Ti and CFR-PEEK carriers were prepared (Table 3).

Table 3.
Main characteristics of heterostructures with AuNPs.
Surface concentrations of AuNPs were 0.6–1.1 (s-series) and 5–6 μg/cm2 (b-series), which were provided by gold loads during PVD experiments (Table 2, column 3). According to XPS data (Figure S1a,b), the gold on the surface was in the metallic state (Au0 4f7/2 with binding energy = 84.0 eV) [23].
Morphological differences were observed for NPs depending on the carrier material. In particular, the ultra-dispersed AuNPs with uniform distribution and an average size of 3 nm were observed on the surfaces of s-Au/CFR-PEEK, s-Au/Ir/CFR-PEEK and s-Au/Pt/CFR-PEEK samples (Figure 1a). At the same time, AuNPs with sizes up to 10 nm were formed under the same conditions on top of the M/Ti surface (e.g., s-Au/Pt/Ti sample, Figure 1c). In turn, 5–6 nm AuNPs and single Au clusters (up to 15 nm) were observed on the surfaces of b-Au/CFR-PEEK, b-Au/Ir/CFR-PEEK and b-Au/Pt/CFR-PEEK samples (Figure 1b). On the contrary, the surface of the b-Au/Pt/Ti sample (Figure 1d) was formed by huge Au clusters (up to 40 nm) and 8–10 nm NPs. The smaller sizes of NPs and/or clusters in the case of CFR-PEEK carriers may be associated with the lower thermal conductivity of this polymer material compared to with the Ti alloy.

Figure 1.
SEM images of s-Au/Pt/CFR-PEEK (a), b-Au/Pt/CFR-PEEK (b), s-Au/Pt/Ti (c) and b-Au/Pt/Ti (d) samples.
3.2. Antibacterial Activity of Heterostructures with AuNPs
Antibacterial activity was evaluated using samples of heterostructures on a CFR-PEEK carrier. In our previous works [21,22], it was shown, using five common strains, which cause perimplant infections, that there is no specific resistance to such heterostructures, i.e., the quantitative effects were similar for all studied bacterial cultures. Therefore, in this work, the effect was studied in relation to only two strains, P. aeruginosa and S. aureus, as important pathogens that are difficult to treat with antibiotics [26,27,28,29]. The processed numerical data for both series after 24 and 48 h of incubation are given in Table 4.

Table 4.
Antibacterial activity of noble metal film heterostructures with AuNPs.
It was shown that all samples completely destroyed the colonies of bacterial cultures of P. aeruginosa and S. aureus after 48 h, whereas no inhibition occurred on the surface of the initial CFR-PEEK. The study after 24 h of exposure revealed the features of the observed antibacterial effect (Figure 2). It was shown that b-Au/Ir/CFR-PEEK and b-Au/Pt/CFR-PEEK samples with a gold concentration of about 5–6 µg/cm2 and nanoparticle sizes up to 5–6 nm had greater activity (<5% of the surviving bacterial colonies compared to the CFR-PEEK reference). s-Au/Ir/CFR-PEEK and s-Au/Pt/CFR-PEEK samples with a noticeably lower gold content (about 1 µg/cm2) also exhibited a noticeable antibacterial effect, but about three times less pronounced.

Figure 2.
Antibacterial activity of s-Au/Ir/CFR-PEEK, s-Au/Pt/CFR-PEEK, b-Au/Ir/CFR-PEEK and b-Au/Pt/CFR-PEEK samples against S. aureus and P. aeruginosa after 24 h * p < 0.0001 (as compared to the CFR-PEEK control sample), # p < 0.0001 (as compared to the CFR-PEEK control sample).
The overall picture of the influence of the studied parameters (surface concentration and size of AuNPs) on the effectiveness of inhibition of bacterial colony growth can be presented with the addition of new results with the data obtained for similar heterostructures from our previous work [22], wherein the sizes of the nanoparticles were 6–9 nm, and their content was maximum (10–11 µg/cm2). The generalized data are presented in Figure 3, where these samples are denoted as Au/M/CFR-PEEK (M = Pt, Ir).

Figure 3.
S. aureus and P. aeruginosa colony counting after 24 h incubation with s-Au/Ir/CFR-PEEK, s-Au/Pt/CFR-PEEK, b-Au/Ir/CFR-PEEK, b-Au/Pt/CFR-PEEK (this work) and Au/Ir/CFR-PEEK, Au/Pt/CFR-PEEK [22] samples depending on the Au content ((a,b) The error of Au concentration determination by ICP-AES does not exceed 10%) and average AuNP sizes ((c,d) The error of average particle size determination estimated using ImageJ does not exceed 25%.).
It should be noted that the antibacterial activity of all samples obtained in this work was noticeably higher than those synthesized earlier [22]. Seemingly, an increase in the size of gold particles in heterostructures of more than 6 nm worsens their antibacterial characteristics despite the higher content of this active component. Thus, the size of the gold nanoparticles has a key influence on antibacterial properties.
The reasons for the observed increased biological effect of new samples may be the better solubility of small-sized particles and the ability of ultrafine gold particles to penetrate into the cell membranes of bacteria, causing their death [30]. At the same time, ultra-small particles (≤2 nm) are the most bioactive, as in s-Au/M/CFR-PEEK and s-Au/Pt/CR-PEAK samples [17,31,32]. However, in our case, they have a less pronounced effect than b-Au/Ir/CFR-PEEK and b-Au/Pt/CFR-PEEK analogues. This suggests that the surface concentration of AuNPs at the level of 1 µg/cm2 is insufficient for effective antibacterial action.
3.3. Characterization of Ir and Pt Coatings Modified with Ag Nanoparticles (AgNPs)
To study the influence of Ag concentration and state on the antibacterial activity of the film heterostructures, two series of samples on Ti and CFR-PEEK carriers were also prepared (Table 5). A standard thermal PVD method was used to deposit this antibacterial component under conditions similar to those described earlier [22]. The surface concentrations of the Ag were 2–6 (s-series) and 17–20 μg/cm2 (b-series), which were provided by silver loads during PVD experiments (Table 2, column 3). It is worth noting that a two-step process of preparing nanostructures was used, namely MOCVD for obtaining the bottom Ir or Pt layer and PVD for its top modification with silver.

Table 5.
Main characteristics of heterostructures with AgNPs or Ag film.
First, in order to demonstrate the possibility of obtaining such heterostructures by the MOCVD method, we conducted test experiments on silver deposition. The advantages of this method are that it does not require a high vacuum (Table 2, column 5) and is more capable of coating the objects of complex shape, such as real medical implants. Currently, interest in the production of antibacterial silver structures by MOCVD is growing [33], but this area still remains relatively undeveloped. In this work, we have chosen such deposition conditions from an available precursor (Table 1 and Table 2) to provide a silver concentration comparable to that of a similar sample obtained by the PVD method (~6 μg/cm2, Table 5).
It is worth noting that the low intense reflexes at 38.2° (111) and 44.5° (200), related to fcc-Ag [34], were observed by the XRD method only for samples with a higher silver content of 17–20 μg/cm2 (i.e., b-series, Table 5). Typical diffraction patterns for such samples are presented in Figure 4. Other reflexes are assigned to the carrier material, e.g., the Ti alloy [35] and CFR-PEEK [36], or the bottom noble metal layer, e.g., fcc-Ir (40.7° (111), 47.3° (200)) [37].

Figure 4.
XRD patterns of b-Ag/CFR-PEEK, b-Ag/Ir/CFR-PEEK, b-Ag/Ti and b-Ag/Ir/Ti.
The XPS data of the Ag–PVD samples corresponded to our previous results [21,22], indicating the presence of silver only in the metallic state (Figure S1c,d). The same was also observed for the analogues obtained by MOCVD, namely for the fitting of Ag 3d (Ag 3d5/2 with a binding energy = 368.2 eV [38]). For example, the data for the s-Ag(CVD)/Ir/Ti sample are shown in Figure 5a. In the as-deposited s-Ag(CVD)/Ir/Ti sample, only the metallic silver phase (Ag 3d5/2 = 368.3 eV) was observed. In addition, the low-intensity silver plasmons were detected on the surface of this sample. Amorphous carbon is the main carbon state detected on the sample surface at 284.2 eV, while another low-intensity carbon state was observed on the sample surface due to the incomplete decomposition of Ag(cod)(hfac) vapor (Figure 5c).

Figure 5.
Sample s-Ag(CVD)/Ir/Ti characterization results: survey XPS spectra (a), Ag 3d spectra (b), C1s + Ir 4d spectra (c), SEM image (d).
The Ir 4f spectrum of the Ag/Ir/Ti sample overlaps with the intense Ag 4p and Ti 3s lines, which leads to large errors in determining the intensity and position of Ir 4f lines. Therefore, Ir 4d spectra were obtained (combined with carbon). According to the Ir 4d spectra, iridium is mainly in the metallic state (64%) and in the oxidized Ir IV state (36%) on the sample surface (Figure 5c). It is worth noting that, during etching at 1 keV, 120 s, the part of the metallic state increases to 83%, and only amorphous carbon is detected in the film. The formation of the surface iridium oxide phase is typical of the conditions used for the depositing iridium films [37].
During deposition by the MOCVD method, AgNPs with a wide size distribution (25–55 nm) are formed on the surface of the titanium carrier, and several such particles can form agglomerates. On the surface of the iridium layer (sample s-Ag(CVD)/Ir/Ti, Figure 5d), smaller particles (16–20 nm) and clusters (up to 40–60 nm) are formed under the same conditions.
Typical microphotographs of PVD samples with different concentrations of silver are shown in Figure 6. There are AgNPs with sizes of 8–15 nm and clusters with sizes of 20–30 nm on the surface of s-Ag/Pt/Ti, s-Ag/Pt/Ti (Figure 6a), s-Ag/Ir/Ti (Figure 6b) samples. At higher silver concentrations, thin discontinuous silver films enveloping the structural elements of Ir, Pt coatings interspersed with individual particles up to 40 nm in size are observed on the surface of b-Ag/Ir/CFR-PEEK (Figure 6c) and b-Ag/Ir/Ti (Figure 6d) samples.

Figure 6.
SEM images of s-Ag/Pt/Ti (a), s-Ag/Ir/Ti (b), b-Ag/Ir/CFR-PEEK (c) and b-Ag/Ir/Ti (d) samples.
3.4. Dynamics of Ag Ions Release and Antibacterial Study of Heterostructures with AgNPs
The active phase of silver release is crucial for the antibacterial effect of coatings [39]. Thus, it has been shown that in the first 1–3 h after implantation, the most active bacterial adhesion occurs, and after 24 h some bacteria already form a biofilm in which they acquire increased resistance [39]. Therefore, it is necessary to ensure a high concentration of the antibacterial agent during the first day to inhibit the initial adhesion of bacteria.
To correctly compare the dynamics of silver ion release from the surface, s-Ag/Ti, s-Ag/Ir/Ti, s-Ag/Pt/Ti and b-Ag/Ir/Ti samples with different silver content were studied (Table 5). The concentration of silver at each time point was normalized to its total concentration in the sample (Co, Table 5, column 2). Thus, for each sample, the dependences of the fraction of silver released from the sample on time were obtained. Typical dependencies are shown in Figure 7.

Figure 7.
The time dependencies of silver fraction change for s-Ag/Ti, s-Ag/Ir/Ti, s-Ag/Pt/Ti and b-Ag/Ir/Ti samples.
A comparative analysis showed that the release of silver into the solution for all samples begins already in the first 2 h and continues throughout the entire time interval. For most samples, the maximum fraction of silver in the solution is reached within 24 h, and then the process is stabilized. However, in the case of b-Ag/Ir/Ti, the fraction of released silver continues to increase, reaching only 0.2 by 48 h. The fraction of silver released from the surface of Ir or Pt films (s-Ag/Ir/Ti and s-Ag/Pt/Ti samples) within 24 h is approximately 2–3 times greater than that for the analog sample on Ti (s-Ag/Ti), which is a consequence of the sacrificial node effect [12,13]. It is worth noting that the fraction of silver released from the b-Ag/Ir/Ti sample within 24 h was minimal (0.1) and lower than for the s-Ag/Ti sample.
The observed differences in the dynamics of silver release from heterostructures are due to the morphological features of the samples (Figure 6). Thus, the surface of the s-series samples is formed by small particles that are more chemically active. The formation of a silver film appears to inhibit the dissolution of the metal even in the presence of an anode pair (b-Ag/Ir/Ti). In general, the nature of the continuous bottom layer had no pronounced effect on the dynamics of silver dissolution. A slightly larger fraction in the case of s-Ag/Pt/Ti may be due to the smaller size of the silver particles and/or its low surface concentration.
After 48 h, the concentration of silver released into the solution (µg/cm2) was 0.6, 1.2, 3.1 and 3.6 for the samples s-Ag/Ti, s-Ag/Pt/Ti, s-Ag/Ir/Ti and b-Ag/Ir/Ti, respectively. It should be emphasized that, in the case of b-Ag/Ir/Ti, i.e., with the formation of a discontinuous film, the process of silver release does not come to stabilization (quasi-equilibrium) under the conditions studied. Thus, the most prolonged delivery of the antibacterial component is expected here. In general, a decrease in the rate of silver release over time, i.e., reaching constant values of Ag concentration, represents a typical picture for biological media and the solutions modelling them [39]. The long-term release of the antibacterial component has a positive effect since it prevents “delayed” infectious complications [40].
A study of the antibacterial activity of the samples (P. aeruginosa and S. aureus, Section 3.2) showed that s-Ag/Ir/Ti and s-Ag/Pt/Ti are characterized by the complete inhibition of the growth of S. aureus and P. aeruginosa already after 24 h (Figure 8). The same behavior is expected to be observed for the s-Ag(CVD)/Ir/Ti analog obtained by the MOCVD method. On the contrary, due to the low fraction of silver in the solution for the b-Ag/Ir/Ti and s-Ag/Ti heterostructures, a partial inhibition of growth is observed in the first 24 h (P. aeruginosa (Colony count 721 ± 29), S. aureus (Colony count 732 ± 29)), and complete inhibition occurs only after 48 h. Thus, there is a direct correlation between the results of in vitro studies and model experiments on the silver release in the biological solution.
Figure 8.
The photos of Petri dishes after 24 h of incubation with bacterial colonies: (1) the control Ti sample with P. aeruginosa, (2) the control Ti sample with S. aureus, (3) the s-Ag/Pt/Ti sample (no growth of P. aeruginosa) and (4) the s-Ag/Pt/Ti sample (no growth of S. aureus).
3.5. In Vivo Biocompatibility and Histological Studies of Heterostructures with AuNPs and AgNPs
The study of the in vivo biocompatibility of implantable materials is associated with the need to gain access into the properties of products in contact with the internal environment of the body. To conduct such studies, subcutaneous implantation of implant samples to laboratory animals is performed at the first stage. For this study, samples with a high concentration of AuNPs or AgNPs were selected, namely b-Au/Pt/CFR-PEEK, b-Ag/Pt/CFR-PEEK and b-Ag/Ir/CFR-PEEK. Implantation was carried out for a period of 1 and 3 months. For comparison, we also used the results of our previous work [22], which presented a 1-month implantation of similar samples with a low concentration of AgNPs (hereinafter, s-Ag/Pt/CFR-PEEK, s-Ag/Ir/CFR-PEEK). In this study, we provide data on their 3-month implantation. All experienced animals restored motor activity 2–3 h after the end of operations and completely restored nutritional and social functions in up to 12 h. No signs of disturbances in the well-being of the animals in the postoperative period were recorded. In the postoperative period, there was no diastasis, suppuration or other complications of the postoperative wound, surrounding tissues and the prostheses. Periodic palpatory examination of the implantation area revealed no signs of swelling, edema of tissues or formation of infiltrates. Examination of each animal before breeding showed that all implants, regardless of the group, were freely located in the subcutaneous space, poorly fixed by surrounding tissues, but did not have any possibility of migration from the implantation area. Based on the collected observational data, it was concluded that there were no general and local inflammatory reactions in the animals to all implanted samples.
According to the results of morphohistological analysis (Table 6), the majority of the samples were characterized by a low level of rejection reaction. Around each implant, the recipient’s body formed a typical fibrous capsule (FC) consisting mainly of collagen fibers. The walls of the FCs were identical in structure from all sides, and their dimensions did not increase during implantation.

Table 6.
Scoring of histological features of pristine and coated CFR-PEEK samples after subcutaneous implantation in rats for 1 and 3 months.
The b-Au/Pt/CFR-PEEK samples caused the formation of the same fibrous capsule as bare CFR-PEEK, but with a slightly higher number of microvessels after 3 months of implantation, which is the preferred parameter. A characteristic of the reaction to b-Au/Pt/CFR-PEEK heterostructures was the presence of single mast cells in a fibrous capsule 1 month after implantation (Figure 9a). Apparently, such cellular migration is the organism’s response to a local increase in the concentration of gold nanoparticles. After 3 months of implantation, such phenomena were no longer observed (Figure 9b). The gold content in the sample decreased to 3 µg/cm2 after 3 months of implantation, i.e., about 40% of the active component was dissolved. For s-Ag/Pt/CFR-PEEK (SI, Figure S2a,b) and b-Ag/Pt/CFR-PEEK samples (Figure 9c,d), the packing density of collagen fibers, the number of macrophages and microvessels were higher than for the corresponding Ir-based heterostructures at both one and three months after implantation. In addition, mast cells and KIT were found in the fibrous capsule around b-Ag/Pt/CFR-PEEK three months after implantation, demonstrating the enhanced biological response to the implant material [41].

Figure 9.
The microscopy images of capsule wall structures of implant samples after 1 month (b-Au/Pt/CFR-PEEK—(a), b-Ag/Pt/CFR-PEEK—(c)) and 3 (b-Au/Pt/CFR-PEEK—(b), b-Ag/Pt/CFR-PEEK—(d)) months of subcutaneous implantation.
Apparently, silver ions act as attractants and induce the migration of cells into the implantation zone. On the contrary, s-Ag/Ir/CFR-PEEK and b-Ag/Ir/CFR-PEEK samples were characterized by minimal signs of rejection reactions. The capsule walls of the samples consist of unidirectional collagen fibers with a moderate typical content of fibroblast cells, while microvessels of usual structure and filling are present in a basic amount (SI, Figure S3a,b). These primary results suggest that the processes of silver release from the surface of Pt and Ir coatings under dynamic environmental conditions of the organism occur in a different way than in model experiments in biological solutions (Section 3.3). Further research is needed to understand these features.
In general, the comparison of the histological characteristics for a series of samples of s-Ag/Pt/CFR-PEEK, s-Ag/Ir/CFR-PEEK, b-Ag/Pt/CFR-PEEK and b-Ag/Ir/CFR-PEEK allows us to note the key influence of the platinum metal and silver concentration on the kinetics of the isolation of the latter and, as a consequence, on the biological compatibility of the samples [42]. Similar to the previous results [20], heterostructures with Ir coatings show the best biocompatibility, even compared to bare CFR-PEEK (e.g., the least dense of the FCs), probably due to the more developed surface of this continuous layer.
For heterostructures with low silver content, an increase in the number of mast cells involved in the development of allergic reactions (0–1 and 1–2 for s-Ag/Ir/CFR-PEEK and s-Ag/Pt/CFR-PEEK, respectively) was observed after one month of implantation. Thus, it can be assumed that a significant dose of silver is released rapidly, causing a negative reaction in the body. This is not observed in samples with higher silver concentration (b-Ag/Ir/CFR-PEEK and b-Ag/Pt/CFR-PEEK). Therefore, a longer release of the antibacterial component Ag in lower concentrations is preferable to improve biocompatibility in vitro. It should be noted that these concentrations are sufficient for the required antibacterial effect. Therefore, heterostructures in the form of discontinuous/island Ag films on a noble metal coating with a developed surface are promising objects for the further development of implant coatings with improved biological properties.
4. Conclusions
This work is a continuation of research on the development of multifunctional film materials based on noble metals for the surface modification of modern TiAl6V4 and CFR-PEEK implants. Such film heterostructures were prepared by gas-phase deposition methods in the form of an antibacterial component, namely AuNPs/AgNPs/Ag discontinuous films on the surface of Pt/Ir continuous layers. The key factors for achieving pronounced antibacterial properties of heterostructures containing AuNPs are the sizes of nanoparticles up to 5–6 nm and the lower limit of the gold content of 1 µg/cm2. It is possible to regulate the achievement of the complete inhibition of bacterial colony growth by controlling the rate of Ag dissolution from the surfaces of film heterostructures by changing the form of antibacterial component (nanoparticles, particle clusters, film). The presence of AuNPs on the surface of the implanted material led to the appearance of mast cells in the fibrous capsule; however, these phenomena disappeared 3 months after implantation. Film heterostructures with an average Ag concentration of 18–20 µg/cm2 (discontinuous film) led to a better in vivo biocompatibility of the materials.
Supplementary Materials
The following supporting information can be downloaded at: https://www.mdpi.com/article/10.3390/coatings13071269/s1, Figure S1: Survey XPS spectra of b-Au/CFR-PEEK (a) and Au 4f spectra (b), XPS spectra of s-Ag/Pt/CFR-PEEK (c) and Ag 3d spectra (d); Figure S2: The microscopy images of capsule walls structure of s-Ag/Pt/CFR-PEEK samples after 1 month (a) and 3 months (b) of subcutaneous implantation; and Figure S3: The microscopy images of capsule wall structures of implant samples after 1 month (s-Ag/Ir/CFR-PEEK—(a), b-Ag/Ir/CFR-PEEK—(c)) and 3 (s-Ag/Ir/CFR-PEEK—(b), b-Ag/Ir/CFR-PEEK—(d)) months of subcutaneous implantation.
Author Contributions
S.I.D., investigation (Pt and Ag/Pt coating preparation and characterization), visualization and writing—original draft preparation; E.S.V., investigation (Ir precursor and Ir, Ag/Ir coating preparation and characterization) and writing—review and editing; D.S.S., writing—original draft, antibacterial tests, preparation and validation; T.Y.G., investigation (ICP-OES analysis, dynamic of Ag ions release); I.V.K., investigation (X-ray study); A.D.F., investigation (X-ray photoelectron study), D.A.N., investigation (SEM of heterostructures); M.B.V., investigation (implantation and histology); E.V.C., investigation (cytotoxicity, antibacterial probes); K.V.Z., writing—original draft preparation; T.V.B., writing—review and editing; N.B.M., conceptualization, funding acquisition, project administration and writing—review and editing. All authors have read and agreed to the published version of the manuscript.
Funding
This research was funded by Russian Sciences Foundation (RSF), Grant Number 20-15-00222-P (Prolongation).
Institutional Review Board Statement
The Local Ethics Committee of the E. Meshalkin National Medical Research Center of the Ministry of Health of the Russian Federation approved all in vivo biocompatibility and histological studies. All parts of the protocol were implemented according to the recommendations on the proper use and care of laboratory animals (European Communities Council Directive 86/609/CEE and the principles of the Declaration of Helsinki). Fifteen pairs of the prepared samples were implanted subcutaneously in Wistar rats (weight of 100–120 g, n = 15).
Informed Consent Statement
Informed consent was obtained from all subjects involved in the study.
Data Availability Statement
The data presented in this study are available in this article or on request from the corresponding author.
Conflicts of Interest
The authors declare no conflict of interest.
References
- Henderson, E.R.; Groundland, J.S.; Pala, E.; Dennis, J.A.; Wooten, R.; Cheong, D.; Windhager, R.; Kotz, R.I.; Mercuri, M.; Funovics, P.T.; et al. Failure mode classification for tumor endoprostheses: Retrospective review of five institutions and a literature review. J. Bone Jt. Surg. Am. 2011, 93, 418–429. [Google Scholar] [CrossRef] [PubMed]
- Bosco, R.; Van Den Beucken, J.; Leeuwenburgh, S.; Jansen, J. Surface engineering for bone implants: A trend from passive to active surfaces. Coatings 2012, 2, 95–119. [Google Scholar] [CrossRef]
- Wang, W.; Zhu, Y.; Liao, S.; Li, J. Carbon Nanotubes Reinforced Composites for Biomedical Applications. Biomed Res. Int. 2014, 2014, 518609. [Google Scholar] [CrossRef] [PubMed]
- Hak, D.J.; Mauffrey, C.; Seligson, D.; Lindeque, B. Use of carbon-fiber-reinforced composite implants in orthopedic surgery. Orthopedics 2014, 37, 825–830. [Google Scholar] [CrossRef]
- Scholz, M.-S.; Blanchfield, J.P.; Bloom, L.D.; Coburn, B.H.; Elkington, M.; Fuller, J.D.; Gilbert, M.E.; Muflahi, S.A.; Pernice, M.F.; Rae, S.I.; et al. The use of composite materials in modern orthopaedic medicine and prosthetic devices: A review. Compos. Sci. Technol. 2011, 71, 1791–1803. [Google Scholar] [CrossRef]
- Chernousova, S.; Epple, M. Silver as antibacterial agent: Ion, nanoparticle, and metal. Angew. Chem. Int. Ed. Engl. 2013, 52, 1636–1653. [Google Scholar] [CrossRef]
- Knetsch, M.L.W.; Koole, L.H. New strategies in the development of antimicrobial coatings: The example of increasing usage of silver and silver nanoparticles. Polymers 2011, 3, 340–366. [Google Scholar] [CrossRef]
- Demann, E.T.K.; Stein, P.S.; Haubenreich, J.E. Gold as an implant in medicine and dentistry. J. Long. Term. Eff. Med. Implants 2005, 15, 687–698. [Google Scholar] [CrossRef]
- Miyazawa, N.; Hakamada, M.; Mabuchi, M. Antimicrobial mechanisms due to hyperpolarisation induced by nanoporous Au. Sci. Rep. 2018, 8, 1–8. [Google Scholar] [CrossRef]
- Marambio-Jones, C.; Hoek, E.M.V. A review of the antibacterial effects of silver nanomaterials and potential implications for human health and the environment. J. Nanoparticle Res. 2010, 12, 1531–1551. [Google Scholar] [CrossRef]
- Aurore, V.; Caldana, F.; Blanchard, M.; Kharoubi Hess, S.; Lannes, N.; Mantel, P.-Y.; Filgueira, L.; Walch, M. Silver-nanoparticles increase bactericidal activity and radical oxygen responses against bacterial pathogens in human osteoclasts. Nanomedicine 2018, 14, 601–607. [Google Scholar] [CrossRef] [PubMed]
- Köller, M.; Bellova, P.; Javid, S.M.; Motemani, Y.; Khare, C.; Sengstock, C.; Tschulik, K.; Schildhauer, T.A.; Ludwig, A. Antibacterial activity of microstructured sacrificial anode thin films by combination of silver with platinum group elements (platinum, palladium, iridium). Mater. Sci. Eng. C 2017, 74, 536–541. [Google Scholar] [CrossRef] [PubMed]
- Köller, M.; Sengstock, C.; Motemani, Y.; Khare, C.; Buenconsejo, P.J.S.; Geukes, J.; Schildhauer, T.A.; Ludwig, A. Antibacterial activity of microstructured Ag/Au sacrificial anode thin films. Mater. Sci. Eng. C 2015, 46, 276–280. [Google Scholar] [CrossRef] [PubMed]
- Radtke, A.; Grodzicka, M.; Ehlert, M.; Jędrzejewski, T.; Wypij, M.; Golińska, P. “To Be Microbiocidal and Not to Be Cytotoxic at the Same Time…”—Silver Nanoparticles and Their Main Role on the Surface of Titanium Alloy Implants. J. Clin. Med. 2019, 8, 334. [Google Scholar] [CrossRef] [PubMed]
- Lampé, I.; Beke, D.; Biri, S.; Csarnovics, I.; Csík, A.; Dombrádi, Z.; Hajdu, P.; Hegedűs, V.; Rácz, R.; Varga, I.; et al. Investigation of silver nanoparticles on titanium surface created by ion implantation technology. Int. J. Nanomed. 2019, 14, 4709–4721. [Google Scholar] [CrossRef]
- Gu, X.; Xu, Z.; Gu, L.; Xu, H.; Han, F.; Chen, B.; Pan, X. Preparation and antibacterial properties of gold nanoparticles: A review. Environ. Chem. Lett. 2021, 19, 167–187. [Google Scholar] [CrossRef]
- Zheng, K.; Setyawati, M.I.; Leong, D.T.; Xie, J. Antimicrobial Gold Nanoclusters. ACS Nano 2017, 11, 6904–6910. [Google Scholar] [CrossRef]
- Avellan, A.; Simonin, M.; McGivney, E.; Bossa, N.; Spielman-Sun, E.; Rocca, J.D.; Bernhardt, E.S.; Geitner, N.K.; Unrine, J.M.; Wiesner, M.R.; et al. Gold nanoparticle biodissolution by a freshwater macrophyte and its associated microbiome. Nat. Nanotechnol. 2018, 13, 1072–1077. [Google Scholar] [CrossRef]
- Zhang, Y.; Shareena Dasari, T.P.; Deng, H.; Yu, H. Antimicrobial Activity of Gold Nanoparticles and Ionic Gold. J. Environ. Sci. Health-Part C Environ. Carcinog. Ecotoxicol. Rev. 2015, 33, 286–327. [Google Scholar] [CrossRef]
- Moreno-Álvarez, S.A.; Martínez-Castañón, G.A.; Niño-Martínez, N.; Reyes-Macías, J.F.; Patiño-Marín, N.; Loyola-Rodríguez, J.P.; Ruiz, F. Preparation and bactericide activity of gallic acid stabilized gold nanoparticles. J. Nanoparticle Res. 2010, 12, 2741–2746. [Google Scholar] [CrossRef]
- Dorovskikh, S.I.; Vikulova, E.S.; Chepeleva, E.V.; Vasilieva, M.B.; Nasimov, D.A.; Maksimovskii, E.A.; Tsygankova, A.R.; Basova, T.V.; Sergeevichev, D.S.; Morozova, N.B. Noble Metals for Modern Implant Materials: MOCVD of Film Structures and Cytotoxical, Antibacterial, and Histological Studies. Biomedicines 2021, 9, 851. [Google Scholar] [CrossRef] [PubMed]
- Dorovskikh, S.I.; Vikulova, E.S.; Sergeevichev, D.S.; Guselnikova, T.Y.; Zheravin, A.A.; Nasimov, D.A.; Vasilieva, M.B.; Chepeleva, E.V.; Saprykin, A.I.; Basova, T.V.; et al. Biological Studies of New Implant Materials Based on Carbon and Polymer Carriers with Film Heterostructures Containing Noble Metals. Biomedicines 2022, 10, 2230. [Google Scholar] [CrossRef] [PubMed]
- Fadeeva, V.P.; Tikhova, V.D.; Nikulicheva, O.N.; Oleynik, I.I.; Oleynik, I.V. Composition determination of post-metallocene olefin polymerization catalysts. J. Struct. Chem. 2010, 51, 186–191. [Google Scholar] [CrossRef]
- Black, K.; Singh, J.; Mehta, D.; Sung, S.; Sutcliffe, C.J.; Chalker, P.R. Silver Ink Formulations for Sinter-free Printing of Conductive Films. Sci. Rep. 2016, 6, 20814. [Google Scholar] [CrossRef]
- Igathinathane, C.; Pordesimo, L.O.; Columbus, E.P.; Batchelor, W.D.; Methuku, S.R. Shape identification and particles size distribution from basic shape parameters using ImageJ. Comput. Electron. Agric. 2008, 63, 168–182. [Google Scholar] [CrossRef]
- Gottenbos, B.; van der Mei, H.C.; Busscher, H.J. Initial adhesion and surface growth ofStaphylococcus epidermidis and Pseudomonas aeruginosa on biomedical polymers. J. Biomed. Mater. Res. 2000, 50, 208–214. [Google Scholar] [CrossRef]
- Rybtke, M.; Hultqvist, L.D.; Givskov, M.; Tolker-Nielsen, T. Pseudomonas aeruginosa Biofilm Infections: Community Structure, Antimicrobial Tolerance and Immune Response. J. Mol. Biol. 2015, 427, 3628–3645. [Google Scholar] [CrossRef]
- Oliveira, W.F.; Silva, P.M.S.; Silva, R.C.S.; Silva, G.M.M.; Machado, G.; Coelho, L.C.B.B.; Correia, M.T.S. Staphylococcus aureus and Staphylococcus epidermidis infections on implants. J. Hosp. Infect. 2018, 98, 111–117. [Google Scholar] [CrossRef]
- Cerioli, M.; Batailler, C.; Conrad, A.; Roux, S.; Perpoint, T.; Becker, A.; Triffault-Fillit, C.; Lustig, S.; Fessy, M.-H.; Laurent, F.; et al. Pseudomonas aeruginosa Implant-Associated Bone and Joint Infections: Experience in a Regional Reference Center in France. Front. Med. 2020, 7, 513242. [Google Scholar] [CrossRef]
- Vimbela, G.V.; Ngo, S.M.; Fraze, C.; Yang, L.; Stout, D.A. Antibacterial properties and toxicity from metallic nanomaterials. Int. J. Nanomed. 2017, 12, 3941–3965. [Google Scholar] [CrossRef]
- Yougbare, S.; Chang, T.K.; Tan, S.H.; Kuo, J.C.; Hsu, P.H.; Su, C.Y.; Kuo, T.R. Antimicrobial gold nanoclusters: Recent developments and future perspectives. Int. J. Mol. Sci. 2019, 20, 2924. [Google Scholar] [CrossRef] [PubMed]
- Wang, Y.; Malkmes, M.J.; Jiang, C.; Wang, P.; Zhu, L.; Zhang, H.; Zhang, Y.; Huang, H.; Jiang, L. Antibacterial mechanism and transcriptome analysis of ultra-small gold nanoclusters as an alternative of harmful antibiotics against Gram-negative bacteria. J. Hazard. Mater. 2021, 416, 126236. [Google Scholar] [CrossRef] [PubMed]
- Piszczek, P.; Radtke, A. Silver Nanoparticles Fabricated Using Chemical Vapor Deposition and Atomic Layer Deposition Techniques: Properties, Applications and Perspectives: Review. In Noble and Precious Metals-Properties, Nanoscale Effects and Applications; Seehra, M.S., Bristow, A.D., Eds.; InTech: Rijeka, Croatia, 2018; Chapter 9; pp. 177–214. ISBN 978-1-78923-293-6. [Google Scholar] [CrossRef]
- Mehta, B.K.; Chhajlani, M.; Shrivastava, B.D. Green synthesis of silver nanoparticles and their characterization by XRD. J. Phys. Conf. Ser. 2017, 836, 012050. [Google Scholar] [CrossRef]
- Kolobov, Y.R.; Zhidkov, M.V.; Golosov, E.V.; Vershinina, T.N.; Kudryashov, S.I.; Makarov, S.V.; Ionin, A.A.; Ligachev, A.E. Phase composition and structure of femtosecond laser-produced oxide layer on VT6 alloy surface. Laser Phys. Lett. 2016, 13, 76103. [Google Scholar] [CrossRef]
- Doumeng, M.; Makhlouf, L.; Berthet, F.; Marsan, O.; Delbé, K.; Denape, J.; Chabert, F. A comparative study of the crystallinity of polyetheretherketone by using density, DSC, XRD, and Raman spectroscopy techniques. Polym. Test. 2021, 93, 106878. [Google Scholar] [CrossRef]
- Vikulova, E.S.; Karakovskaya, K.I.; Koretskaya, T.P.; Korolkov, I.V.; Chepeleva, E.V.; Asanov, I.P.; Tsygankova, A.R.; Maksimovskii, E.A.; Marchenko, E.S.; Lantsukhay, Y.A.; et al. MOCVD of Noble Metal Film Materials for Medical Implants: Microstructure and Biocompatibility of Ir and Au/Ir Coatings on TiNi. Coatings 2021, 11, 638. [Google Scholar] [CrossRef]
- Gambardella, A.; Berni, M.; Graziani, G.; Kovtun, A.; Liscio, A.; Russo, A.; Visani, A.; Bianchi, M. Nanostructured Ag thin films deposited by pulsed electron ablation. Appl. Surf. Sci. 2019, 475, 917–925. [Google Scholar] [CrossRef]
- Jamuna-Thevi, K.; Bakar, S.A.; Ibrahim, S.; Shahab, N.; Toff, M.R.M. Quantification of silver ion release, in vitro cytotoxicity and antibacterial properties of nanostuctured Ag doped TiO2 coatings on stainless steel deposited by RF magnetron sputtering. Vacuum 2011, 86, 235–241. [Google Scholar] [CrossRef]
- Kargupta, R.; Bok, S.; Darr, C.M.; Crist, B.D.; Gangopadhyay, K.; Gangopadhyay, S.; Sengupta, S. Coatings and surface modifications imparting antimicrobial activity to orthopedic implants. WIREs Nanomed. Nanobiotechnology 2014, 6, 475–495. [Google Scholar] [CrossRef]
- Alsaleh, N.B.; Mendoza, R.P.; Brown, J.M. Exposure to silver nanoparticles primes mast cells for enhanced activation through the high-affinity IgE receptor. Toxicol. Appl. Pharmacol. 2019, 382, 114746. [Google Scholar] [CrossRef]
- Breisch, M.; Loza, K.; Pappert, K.; Rostek, A.; Rurainsky, C.; Tschulik, K.; Heggen, M.; Epple, M.; Tiller, J.C.; Schildhauer, T.A.; et al. Enhanced dissolution of silver nanoparticles in a physical mixture with platinum nanoparticles based on the sacrificial anode effect. Nanotechnology 2019, 31, 55703. [Google Scholar] [CrossRef] [PubMed]
Disclaimer/Publisher’s Note: The statements, opinions and data contained in all publications are solely those of the individual author(s) and contributor(s) and not of MDPI and/or the editor(s). MDPI and/or the editor(s) disclaim responsibility for any injury to people or property resulting from any ideas, methods, instructions or products referred to in the content. |
© 2023 by the authors. Licensee MDPI, Basel, Switzerland. This article is an open access article distributed under the terms and conditions of the Creative Commons Attribution (CC BY) license (https://creativecommons.org/licenses/by/4.0/).









